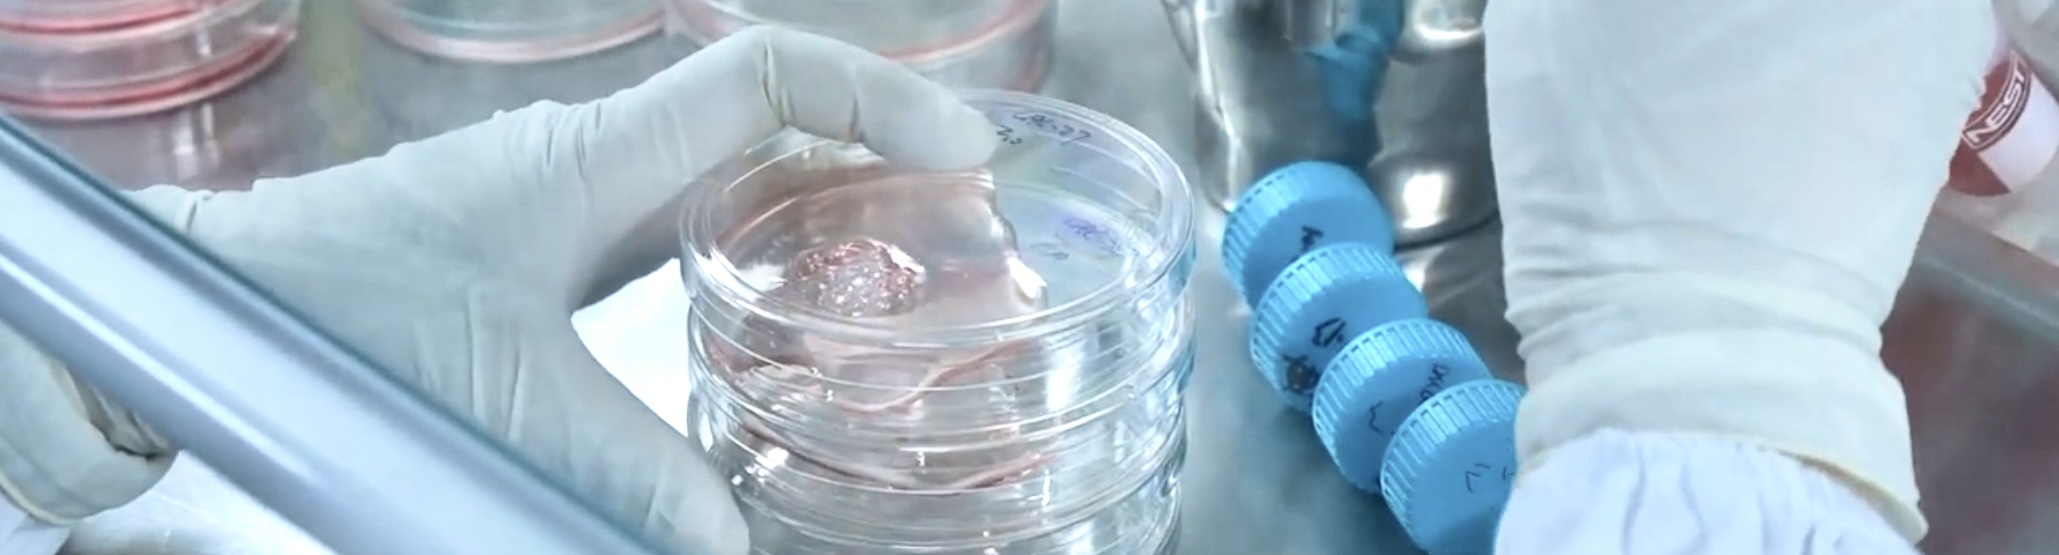

Research experience
Dual functionalized iRGD-Modified liposomes for the co-delivery of two drugs to enhance radiosensitivity in glioblastoma (GBM)
Master's thesis, project is ongoing...
Glioblastoma is a highly malignant central nervous system tumor.
Surgical resection combined with radiotherapy and temozolomide chemotherapy is currently the first-line treatment.
However, many challenges arise during treatment, such as drug resistance and radioresistance.
My research utilizes a radioresistant cell line model established in previous studies.
By integrating bioinformatics approaches, I investigate the changes in signaling pathways within the radioresistant cells and select two drugs targeting these pathways.
To achieve targeted drug delivery to glioblastoma, I developed a liposome modified with the iRGD peptide.
iRGD can bind to CD51/CD61 and CD304 on the surface of GBM cells, mediating the endocytosis of the liposomes and enabling targeted drug delivery.
Additionally, iRGD receptors are also expressed in the tumor's neovasculature, facilitating the penetration of liposomes into the tumor.
In this study, I constructed iRGD-modified dual-drug liposomes and conducted a series of characterizations. The results indicated that the liposomes I developed are stable, with uniform particle size and good morphology. In vitro experiments demonstrated that the iRGD-modified liposomes exhibit excellent targeting capability towards tumor cells. Furthermore, in vitro evaluations showed that these liposomes can enhance the radiosensitivity of glioblastoma. In vivo experiments with the liposome combined with radiotherapy significantly inhibited tumor growth in nude mice, improved the effects of radiotherapy, and extended the survival time of the mice.
Currently, histological-related experiments are still ongoing. Meanwhile, I am organizing data and writing the manuscript...

Construction of a tumor immunity related clinical prediction model for glioblastoma (GBM) based on lncRNA using the TCGA database.
This is an independent training project aimed at enhancing my skills in the field of bioinformatics.
I utilized primary tumor sample data from the TCGA database for glioblastoma (GBM). By conducting ssGSEA scoring based on a dataset comprised of 32 gene sets,
I classified the samples into two subtypes according to their scores.
I then extracted the lncRNAs and applied the WGCNA method to identify a series of co-expression modules.
I evaluated the core genes within the modules that exhibited high module membership (MM) and high gene significance (GS),
exploring the correlation between these core genes and a variety of immune-related gene expressions, performing enrichment analysis of highly correlated genes,
and analyzing survival differences following consensus clustering.
Subsequently, I selected the blue module for analysis. I constructed a clinical prediction model using Lasso regression and assessed the prognostic value of risk features through COX regression analysis.
Based on the model, I employed package OncoPredict for drug sensitivity prediction. The analysis revealed that the high-risk group exhibited a significantly lower IC50 for Erlotinib.
Based on the analysis results, I evaluated the efficacy of Erlotinib in different glioblastoma cell lines, including U87, U251, and U118. I found that Erlotinib showed good efficacy against these cell lines, and when used in combination with Temozolomide, there was a slight synergistic effect.
This is an independent research training program that draws inspiration from previously published articles, though it still has many shortcomings, such as not splitting the TCGA data into internal training and validation sets for model construction and validation, and not using external datasets to verify the model's reliability. Additionally, the COX regression analysis is incomplete.
However, this project has significantly improved my bioinformatics skills, especially my proficiency in R, and has also trained my scientific thinking.
Development of a radiotherapy resistant stem cell model in glioblastoma (GBM) cell lines through repeated radiation screening: Isolation, identification, and investigation of resistance mechanisms
The project has been completed, and the manuscript is being prepared...
In this study, I established a radioresistant glioblastoma cell line. The specific approach involved isolating glioblastoma stem cells (GSCs) from the U87 cell line and treating the GSCs with a 5 Gy dose of radiotherapy, selecting for surviving cells, a process that was repeated 13 times. Ultimately, a radioresistant GSC cell line was obtained. Validation showed that this cell line highly expresses several stem cell markers, such as CD133 and SOX2.
To further simulate the role of GSCs within the tumor, I induced differentiation in the GSCs. The differentiated cells were named Diff cells. Through in vitro validations, including cell viability assays and apoptosis tests, I found that Diff cells exhibited a significantly greater insensitivity to radiotherapy compared to U87 cells. Additionally, I discovered that Diff cells demonstrated markedly lower sensitivity to TMZ compared to U87 cells, suggesting a possible link between radioresistance and drug resistance.
Finally, I performed whole transcriptome sequencing on U87, GSCs, and Diff cells for bioinformatics analysis, laying the foundation for subsequent research.
Showcase


Activities
Attended an academic conference

Enjoys life
Flowers and love

Recent photo

My Cat!
She's just adorable, isn't she?